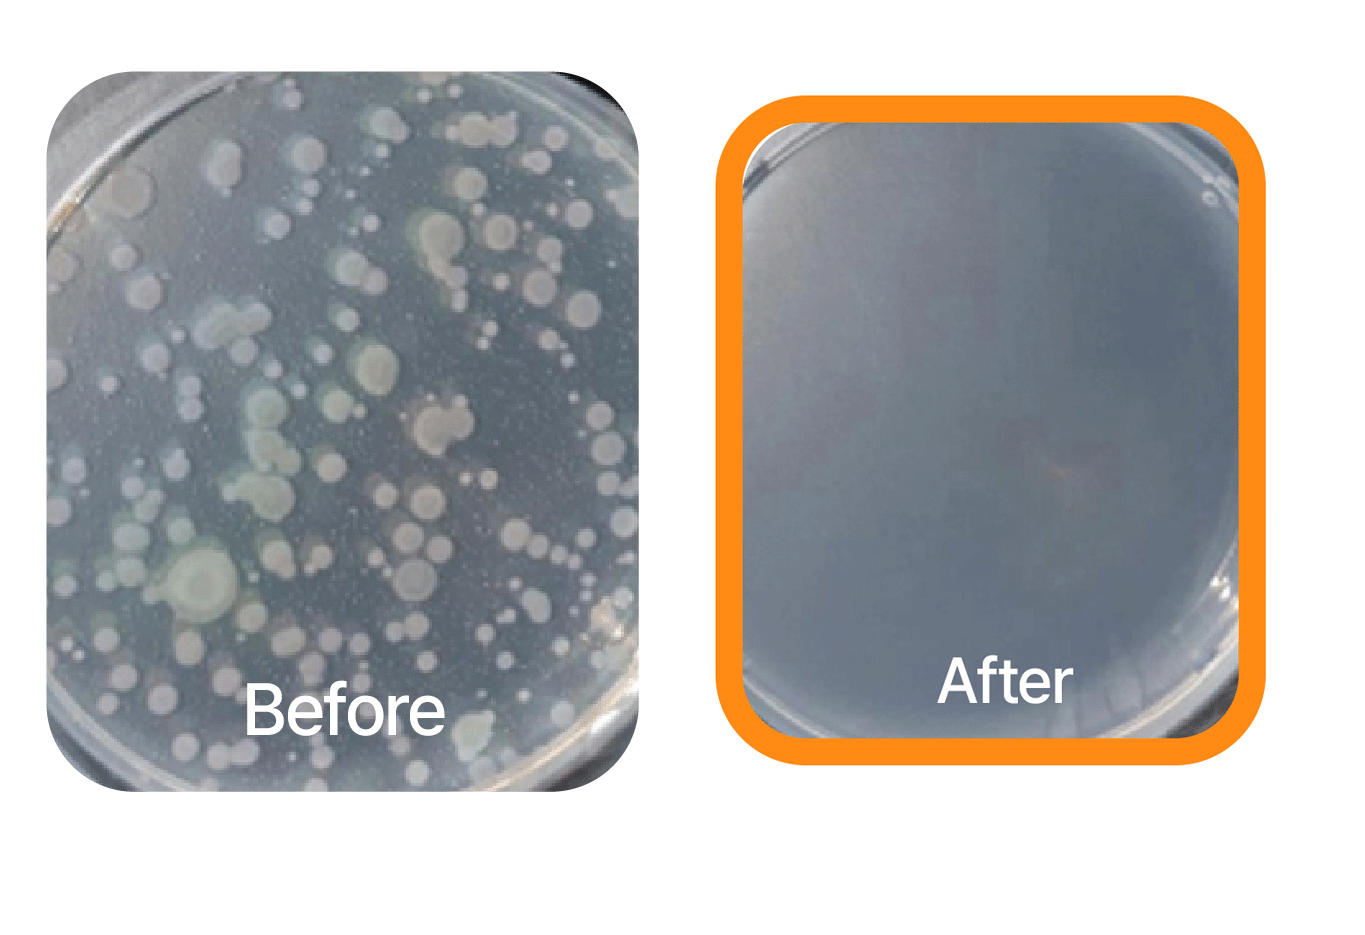
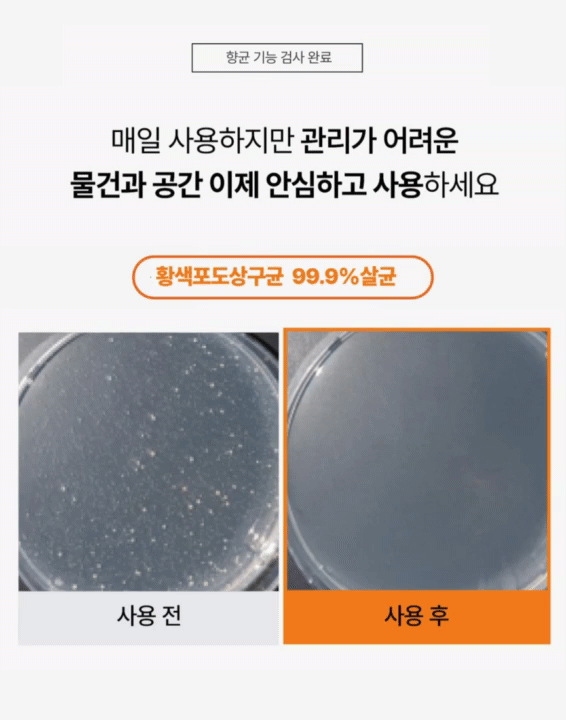

성공금 사용 계획
먼슬리121는 펀딩 성공금은 신제품 개발에 사용됩니다.
WHY WADIZ?
서포터들과의 가까운 소통을 통해 제품을 발전시키고 함께 성장하기 위해 먼슬리원투원의 제품은 항상 와디즈에서 제일 먼저 선보이고 있습니다. 앞으로도 여러분들과의 가까운 소통을 통해 더 나은 제품으로 돌아올 약속을 드립니다.
반환 정책 및 교환A/S 정책
• 서포터 부주의로 인한 손상 또는 박스 개봉시 교환/ 반환/반품이 불가능합니다.
• 교환 및 성공금 반환 기간인 7일이 경과된 제품인 경우교환이 불가능합니다.
• 교환 요청 시 와디즈 메시지 또는 CJS센터070.7178.8899 로 문의 부탁드립니다.
• 이 외의 모든 사항은 와디즈 운영 정책을 따릅니다.
배송 방법
• 한진택배 배송을 통해 순차적 발송
• 도서/산간지방의 경우 배송비 3,000원 을 추가로 펀딩해주세요.
• 배송 관련 문의 카카오톡 플러스 친구 : 먼슬리121
*문의는 평일 10:00 ~ 17:00 에 가능합니다
 monthly121
monthly121
